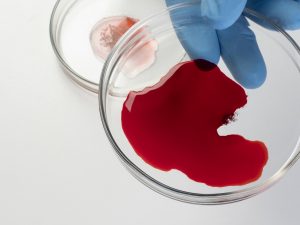

Curso Limpieza en Colegios
185.00 € El precio original era: 185.00 €.135.00 €El precio actual es: 135.00 €.
Duración del curso: 220 horas
📌 Modalidad: A distancia
📌 Modalidad: Online – Plataforma Virtual
📚 Formato libro: Solo 40 € + – 🛒 [Pincha aquí para agregar al carrito]
Solicitar información

Curso Limpieza en Colegios
185.00 € El precio original era: 185.00 €.135.00 €El precio actual es: 135.00 €.
- Descripción
Descripción
🧹🏫
📌 Descripción del curso
La limpieza en los colegios es un pilar fundamental para garantizar la salud, el bienestar y la seguridad de toda la comunidad educativa. Con este curso aprenderás las técnicas, productos y procedimientos adecuados para mantener los centros escolares en óptimas condiciones higiénicas.
📘 Temario del curso
🏫 UNIDAD DIDÁCTICA 1. CONTEXTO SOCIAL DE LA LIMPIEZA EN CENTROS ESCOLARES
-
Introducción
-
¿Por qué es importante la limpieza en colegios?
-
¿En qué consiste la limpieza en colegios?
👩🔧 UNIDAD DIDÁCTICA 2. ENTORNO PROFESIONAL DEL PERSONAL DE LIMPIEZA EN CENTROS ESCOLARES
-
Reglas fundamentales en el trabajo de la limpieza
-
Las relaciones con el entorno profesional
🧴 UNIDAD DIDÁCTICA 3. CONOCIMIENTOS SOBRE PRODUCTOS
-
Importancia de los productos
-
Estudio del pH
-
El agua
-
Clasificación de productos
-
La dosificación de productos
-
Interpretación de las etiquetas de los productos
🧼 UNIDAD DIDÁCTICA 4. CONOCIMIENTOS SOBRE SUCIEDAD, LIMPIEZA, DESINFECCIÓN Y SUPERFICIES
-
Conceptos de suciedad, limpieza y desinfección
-
Clases de suciedad, limpieza y desinfección
-
Clases de materiales de las superficies
🧽 UNIDAD DIDÁCTICA 5. TÉCNICAS Y UTENSILIOS DE LIMPIEZA DE CENTROS ESCOLARES
-
Las tareas de limpieza y desinfección
-
La maquinaria y los utensilios de limpieza y desinfección
🧪 UNIDAD DIDÁCTICA 6. MÉTODOS DE LIMPIEZA Y DESINFECCIÓN EN CENTROS ESCOLARES
-
Clasificación de las zonas de un colegio
-
Métodos de limpieza y desinfección por zonas
-
Periodicidad de la limpieza
🎯 ¿Qué vas a lograr con este curso?
-
Conocer la importancia de la higiene en los colegios y su impacto en la salud.
-
Dominar el uso y la dosificación correcta de productos de limpieza y desinfección.
-
Identificar los tipos de suciedad y superficies para aplicar el método más adecuado.
-
Aprender el manejo de utensilios y maquinaria de limpieza profesional.
-
Adquirir técnicas eficaces de limpieza y desinfección por zonas escolares.
-
Mejorar las competencias profesionales para un trabajo más eficiente y seguro.
👥 ¿A quién va dirigido?
-
✅ Personas que deseen trabajar como personal de limpieza en colegios o centros educativos.
-
✅ Profesionales del sector de la limpieza y servicios generales que quieran especializarse en entornos escolares.
-
✅ Empresas y servicios de limpieza que necesiten formar a su personal.
-
✅ Cualquier persona interesada en adquirir conocimientos prácticos en limpieza y desinfección de centros escolares.
ref EF_186143-1603
Administración y gestión
Trabajamos con las empresas del sector para generar las mejores ofertas de cursos que ponemos a tu disposición.
Sé el primero en valorar “Curso Limpieza en Colegios” Cancelar la respuesta
Artículos Vistos Recientemente
Curso de Teleemergencias
Curso en Hematología y Hemoterapia
Curso Experto en Dirección de Centros Educativos
Curso Ayudante de Cocina en Colectividades (Hospitales-Residencias-Colegios-Comedores Colectivos)
Curso Prestación de Servicios Bibliotecarios
Nuestro Instagram
Recibe tu curso en casa
Con total confianza
Paga con tarjeta o a Plazos
Pago 100% Seguro
LLamanos
Consultanos tus dudas

Valoraciones
No hay valoraciones aún.